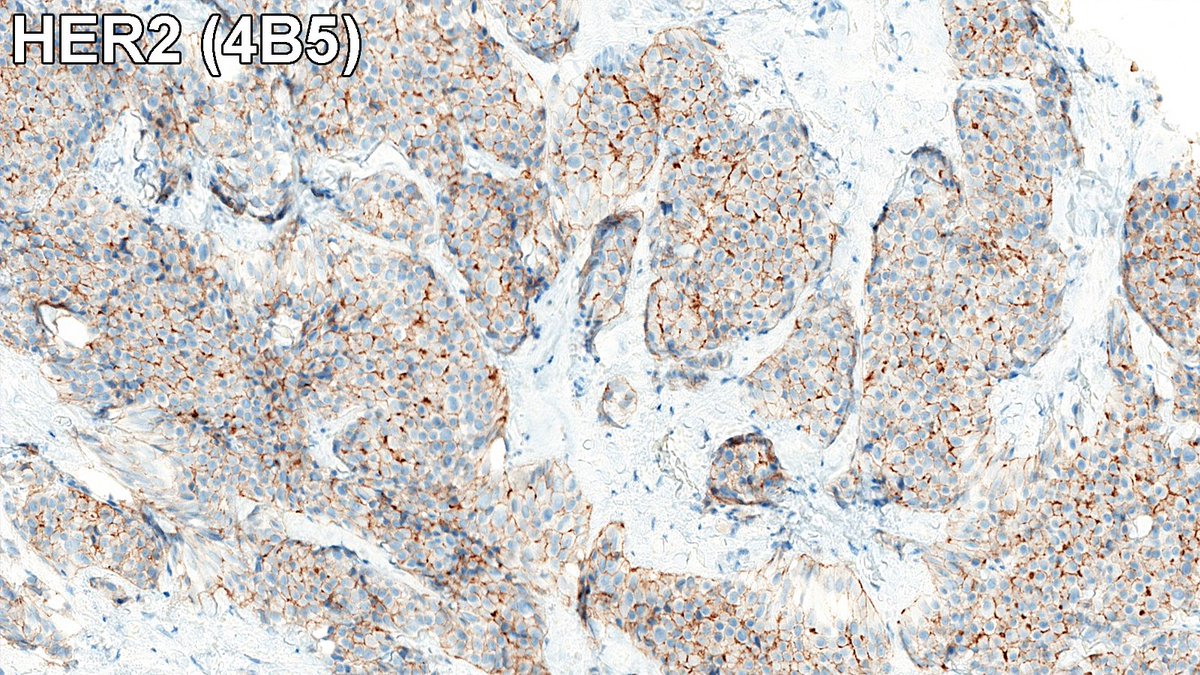
Raza Hoda MD tweet media
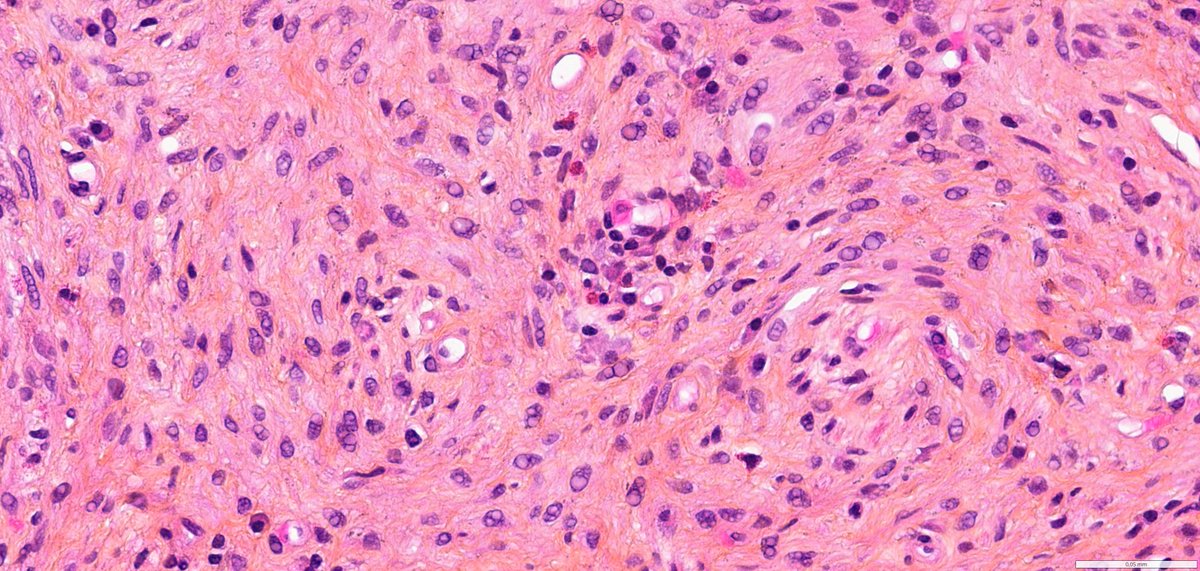
Ana-Maria Catana tweet media

Ana-Maria Catana ری ٹویٹ کیا

Brave New World of Breast Pathology 🧑🏫
HER2 interpretation is increasingly complex—with evolving definitions come real challenges, especially reproducibility. We’ll cover navigating HER2-low & ultralow in a clinically meaningful way.
#PathX #PathTwitter #breastpath #USCAP2026
English